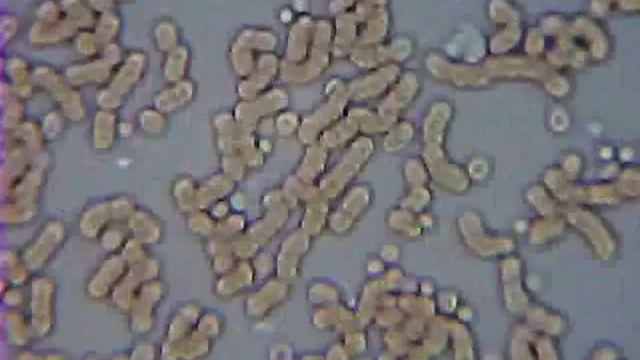
Здоровая и больная клетка крови под микроскопом смотреть онлайн

Автор: Делай То, Что Дарит Счастье Страница 3

КАК ВАРИТЬ, ЧИСТИТЬ, И ЕСТЬ РАКОВ? ЛОВЛЯ РАКОВ С МАСКОЙ, И С ФОНАРИКОМ!

Вскрылась страшная правда! «США устроили землетрясения в Турции с помощью проекта HAARP»

Пряжа для малышей

Emmy Rossum,Justin Chatwin,Emma Kenney, in Shameless - coffee and suger

Роторная пломба, как выглядит, применение
Здоровая и больная клетка крови под микроскопом

ОБРЕЗКА ЛИСТЬЕВ ТОМАТА В НОЯБРЕ, КАК ПОЛИВАТЬ ТОМАТ ЧТОБ ОН НЕ ТРЕСКАЛСЯ! 23.11.2022

4 способа спрятать деньги у себя дома

Госуслуги. Оформление загранпаспорта.

Подземелье Кремля, прохождение, часть 1

Умные швейные приемы для повышения квалификации

ПОДЛОСТИ МОЕГО ЕГИПЕТСКОГО МУЖА ПРОДОЛЖАЮТСЯ/ ЕГИПЕТСКИЕ ДЕВУШКИ (рус. субтитры)

?КАК ИГРАТЬ В МОЩНЫЕ ИГРЫ НА СЛАБОМ ПК или НОУТБУКЕ в 2023 Far Cry 6,Battlefield 2042,Genshin impac

РАЗРЫВЫ В РОДАХ | ЭПИЗИОТОМИЯ | ПОДГОТОВКА К РОДАМ | ПЛАЦЕНТАРИУМ

Сменил прописку - меняй и ПТС

1С-UMI. Инструкция как заработать, продавая сайты 28.04.2020

Круиз в Кронштадт

/Рисуем космос/

Японский чай Матча Способ заваривания

WikiLeaks parody of MasterCard ad... priceless

Учим числа с 1 до 100 - russische Zahlen hören und lesen

ЛУЧШИЙ СОВЕТ для Становой Тяги от Рекордсмена Мира | СТАНОВАЯ НА МАКСИМУМ

ЩАВЕЛЕВЫЙ СУП В МУЛЬТИВАРКЕ MARUCHI RW-FZ45F

Видео обзор - Таблица демонстрационная "Растворимость солей, кислот и оснований в воде" (100х140)
За каждым успешным каналом стоит личность, идея и сотни часов кропотливого труда. Если вы здесь, значит, автор «Делай То, Что Дарит Счастье» уже сумел зацепить ваше внимание своим уникальным стилем или подачей. А мы на RUVIDEO позаботились о том, чтобы вы могли изучить весь архив его работ в максимально комфортных условиях — без лишней суеты и преград.
Почему за работами канала «Делай То, Что Дарит Счастье» так интересно наблюдать? Всё просто: это честный контент, который находит отклик в сердцах зрителей. На нашем ресурсе вы можете смотреть онлайн все видео любимого автора бесплатно и в хорошем качестве. Нам важно, чтобы вы видели каждую деталь и слышали каждый нюанс, поэтому мы используем только стабильные плееры из открытых источников Rutube.
Следите за новинками канала, пересматривайте старые шедевры и открывайте для себя новые грани творчества «Делай То, Что Дарит Счастье». Мы постоянно обновляем ленту, чтобы у вас под рукой всегда были самые свежие выпуски. Никаких сложных регистраций — только вы и творчество, которое вдохновляет. Приятного вам путешествия по миру авторского контента на RUVIDEO!
Видео взято из открытых источников Rutube. Если вы правообладатель, обратитесь к первоисточнику.